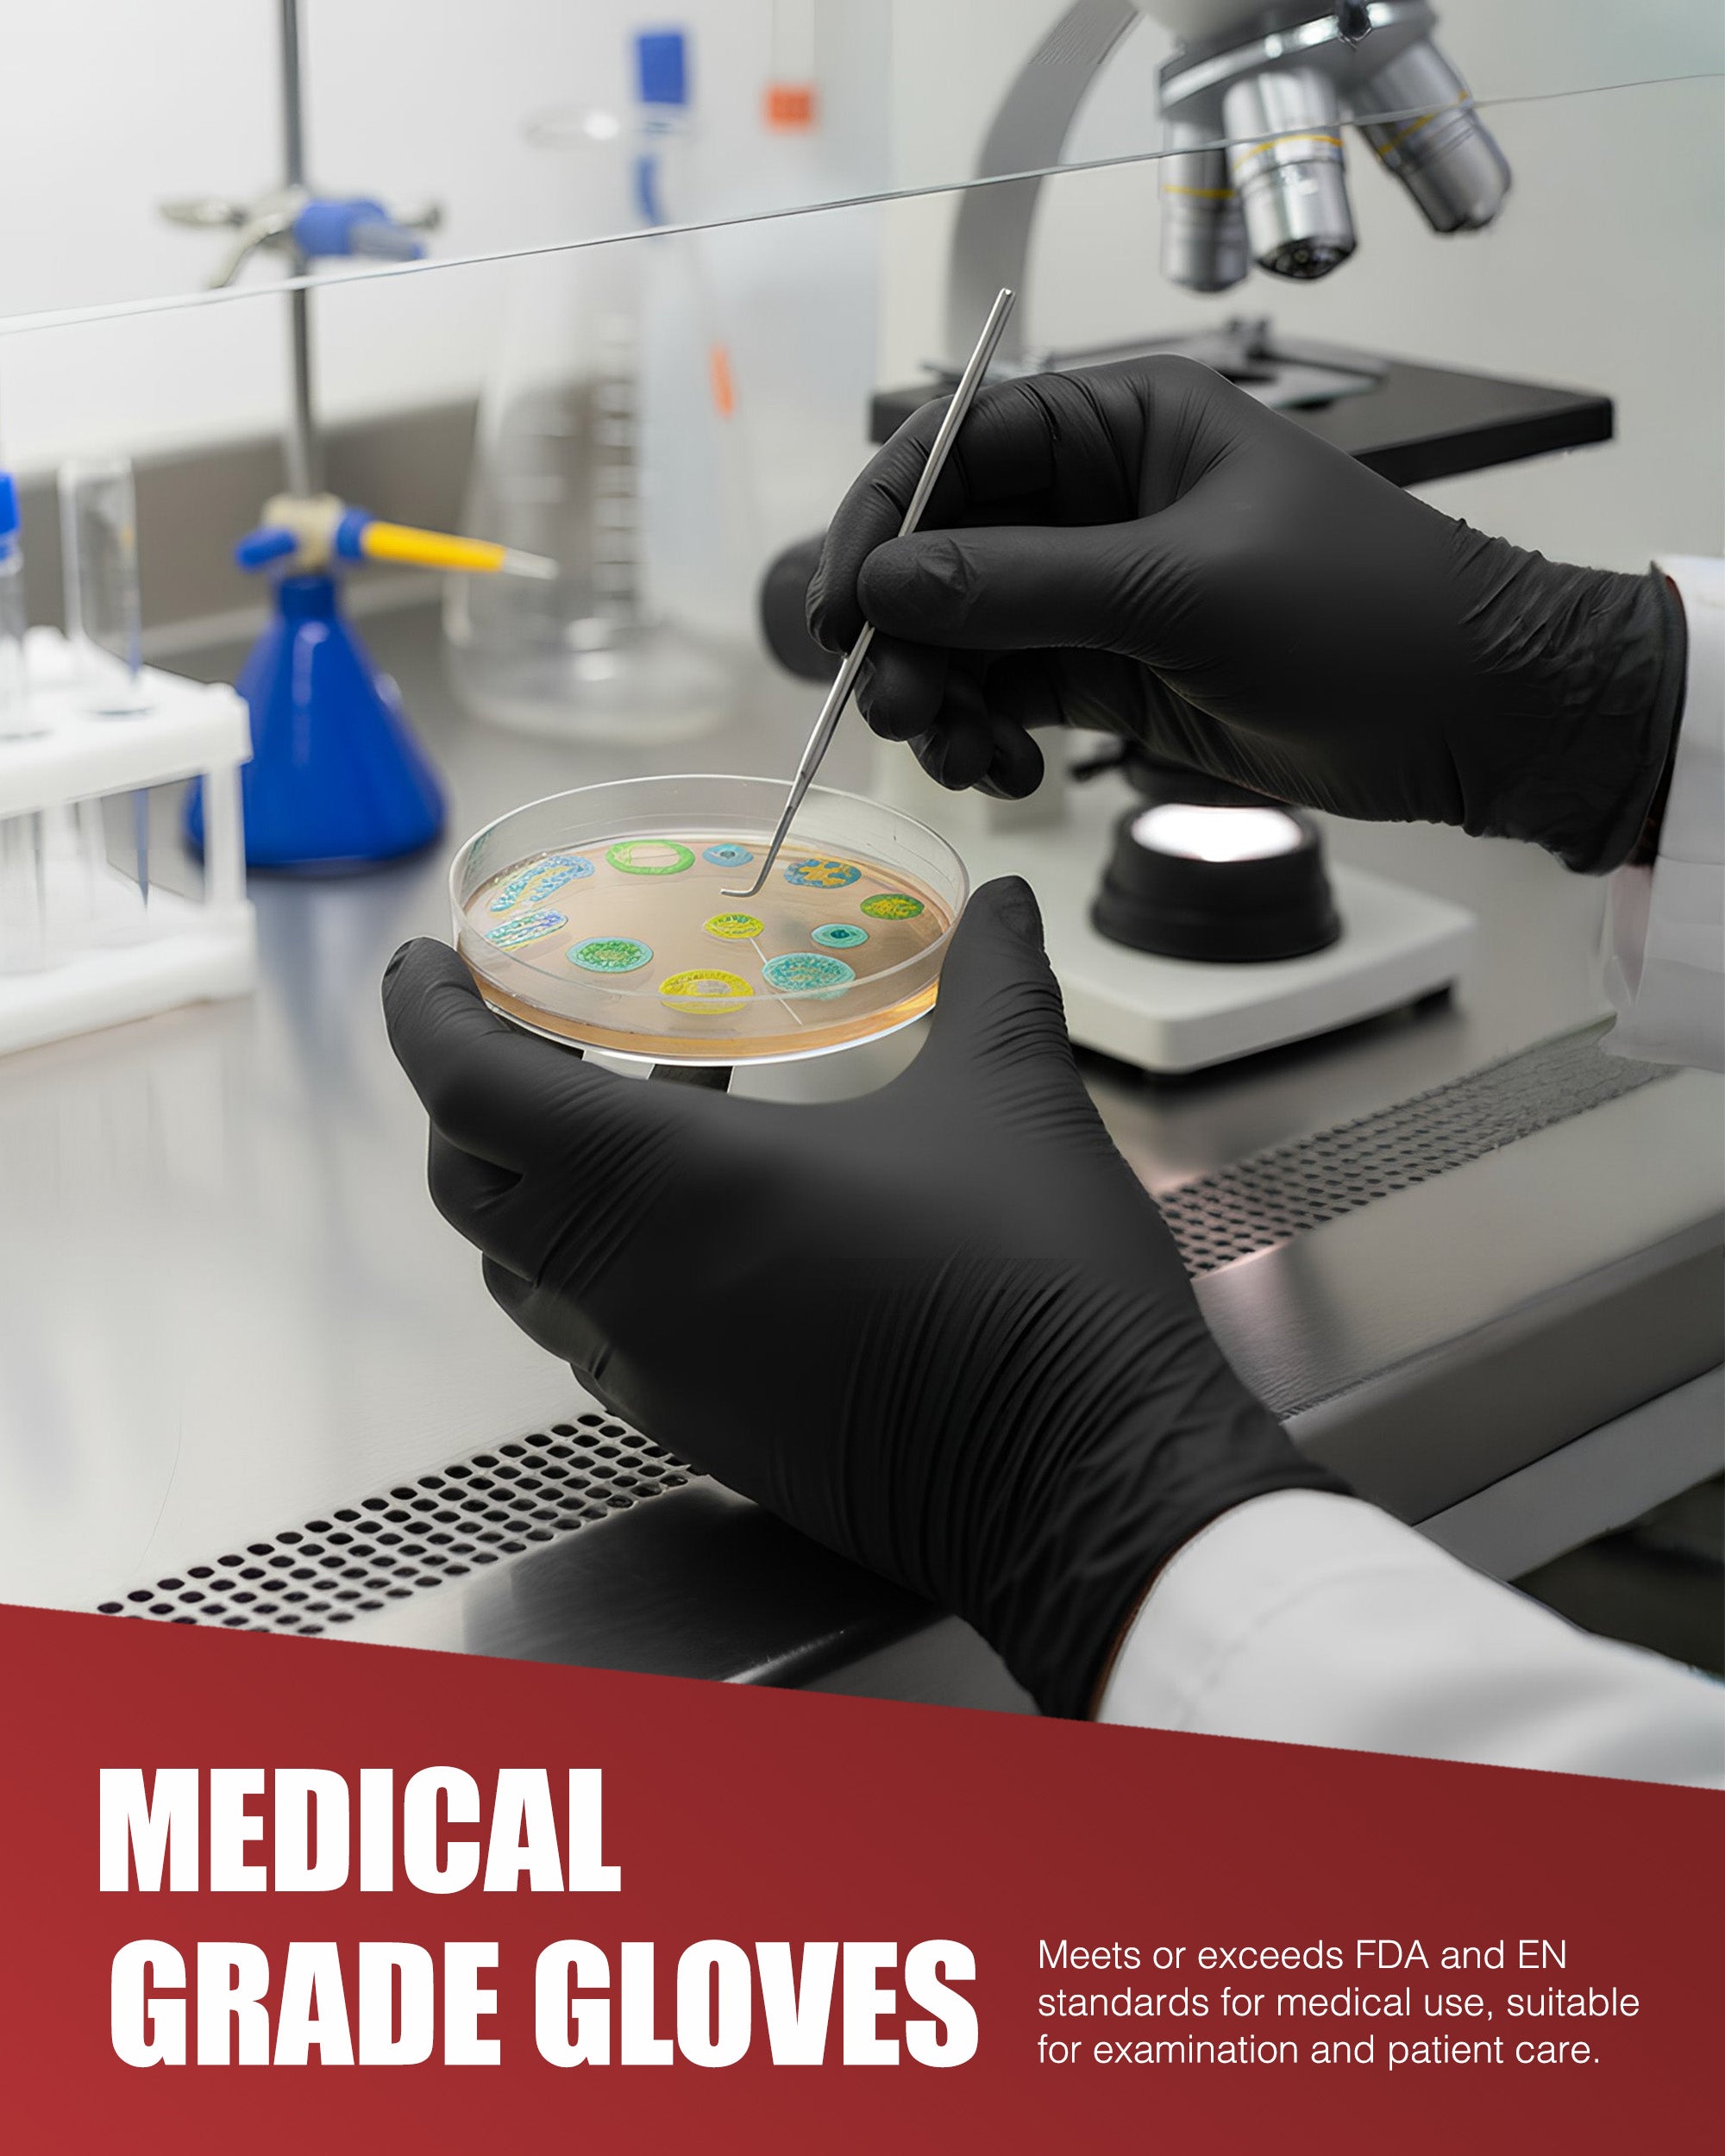
Merrimen Nitrile Gloves - BLACK | Disposable – Box of 100 | Ambidextrous Nitrile Gloves | Latex & Powder Free | For Safe Hands Against Allergies

Merrimen Nitrile Gloves - BLACK | Disposable – Box of 100 | Ambidextrous Nitrile Gloves | Latex & Powder Free | For Safe Hands Against Allergies
Description
- Material: Made from high-quality synthetic nitrile rubber for superior durability and flexibility
- Powder-Free: Eliminates the risk of powder-related contamination and allergic reactions
- Medical Grade: Meets or exceeds FDA and EN standards for medical use, suitable for examination and patient care
- Latex-Free: Safe for users with latex allergies or sensitivities
- Disposable: Single-use to maintain hygiene standards
Next day delivery available
18+, T&C apply, Credit subject to status Learn more


























